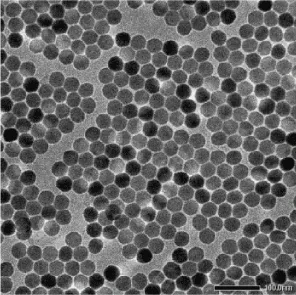

International Journal of Nanomaterials, Nanotechnology and Nanomedicine
Monodisperse Water-Stable Sio2- Coated Fluoride Upconversion Nanoparticles with Tunable Shell Thickness
1School of Chemistry and Chemical Engineering, Harbin Institute of Technology, Harbin, Heilongjiang 150001, People’s Republic of China
2The Second Affiliated Hospital of Guangzhou Medical University, Guangzhou 510260, People’s Republic of China
#Co-first authors, these authors contributed equally to this work
Author and article information
Cite this as
Ji T, Xu X, Wang X, Zhou Q, Chen G (2017) Monodisperse Water-Stable Sio2- Coated Fluoride Upconversion Nanoparticles with Tunable Shell Thickness. Int J Nanomater Nanotechnol Nanomed. 2017; 3(1): 15-18. Available from: 10.17352/2455-3492.000015
Copyright License
© 2017 Ji T, et al. This is an open-access article distributed under the terms of the Creative Commons Attribution License, which permits unrestricted use, distribution, and reproduction in any medium, provided the original author and source are credited.Monodisperse water-stable silica functionalization of upconversion nanoparticles are important for their applications in bio-imaging and bio-sensing. Here, we report on the uniform silica coating of NaYF4:Yb,Er,Tm upconversion nanoparticles (UCNPs) with a controlled thickness (3-16 nm) through a modified reverse microemulsion approach. We show that the molar ratio between tetraethylorthosilicate (TEOS) and UCNPs is important to tune the resulting thickness of silica, which can be controlled via simple increase of the concentration of UCNPs while maintaining the TEOS concentration constant. Our results show that those silica-coated upconversion nanoparticles are stable at pH = 7 sodium chloride-free solution, important for their bio-applications.
In recent years, with the deepened understanding of the luminescence mechanism of lanthanide-doped upconversion nanoparticles (UCNPs) and the maturity of their synthesis methods, those new luminescent nanomaterials have spurred wide interests on many applications ranging from biomarker detection to biomedical imaging [1-10]. UCNPs have many excellent physical and chemical properties, such as infrared light excitation, strong penetrability of tissue, little damage to biological tissue, zero background fluorescence, long fluorescence lifetime, narrow emission band, and wide anti-Stokes shift and so on. However, the as-prepared UCNPs are typically hydrophobic (water-insoluble) and unable to link with bio-targeting biomolecules, restricting their applications in biology. For example, the solvo (hydro) thermal method and thermal decomposition method are commonly used approaches for synthesizing monodisperse UCNPs with good reproducibility [11-14]. Yet, the long-chain oleic acid capped on the surface prevent their further uses in biological environment. To solve this problem, the surface chemistry of as-prepared UCNPs have to be designed to grant both a stable aqueous colloidal dispersion and the ability to conjugate biomolecules. Several approaches has been attempted toward this regard, including SiO2 coating, wrapping by small molecular surfactant, amphiphilic polymer, oxidizing oleic acid ligands with the Lemieuxvon Rudolf reagent, and ligand exchange [11,15-25]. In particular, SiO2-coating are of particular interest, due to its high biocompatibility, easy surface modification through silicon-enriched chemistry, and easy control of interparticle interactions [26-29]. However, there lacks a facile way to perform silica coating of UCNPs with a controlled thickness.
Herein, we used a high temperature co-precipitation method to synthesize hexagonal NaYF4: Yb, Er, Tm UCNPs capped by the oleic acid group. These UCNPs were then coated with a silica shell of different thickness via a modified reverse microemulsion. Moreover, we found that all these silica-coated UCNPs are stable at pH = 7 biological physiological saline (the sodium chloride NaCl solution).
Materials and Methods
Materials and characterization
Rare-earth oxides, including yttrium chloride (YCl3.6H2O, 99.99%), ytterbium chloride (YbCl3.6H2O, 99.99%), erbium chloride (ErCl3.6H2O, 99.99%), Thulium chloride (TmCl3.6H2O, 99.99%) Triton X-100, ammonia solution (25-28%) and tetraethyl orthosilicate (TEOS, 99.99%) were purchased from Aladdin (Shanghai, China). Other reagents (analytical grade) were also purchased from Aladdin (Shanghai, China). All reagents were used as received without further purification. Deionized water was used in all experiments. TEM images were performed on a JEM 2000FX (Jeol Ltd, Japan). Fluorescence spectra were recorded on Ocean optics spectrometers equipped with a near-infrared (NIR) laser with emission at 980 nm.
Synthesis of NaYF4: Yb,Er,Tm upconversion nanoparticles
The NaYF4: 20% Yb, 2% Er, 0.5% Tm nanocrystals were prepared using a high temperature co-precipitation method. First, the lanthanide chlorides containing 0.775 mmol YCl3.6H2O, 0.20 mmol YbCl3.6H2O, 0.02 mmol ErCl3.6H2O, 0.005 mmol TmCl3.6H2O were loaded to a 250 mL 3-necked flask, followed by adding 15 mL of octadecene and 9 mL of oleic acid. The flask was then heated to 150 under Ar for 30 min. Subsequently, the flask was cooled down to 50 and 10 mL methanol solution containing 0.1482 g NH4F and 0.1 g NaOH was added drop wise. The mixed solution was stirred at 50 for 2 h and heated slowly to 80 to remove methanol. The flask was heated up rapidly to 300 for 1 h, and then naturally cooled down to room temperature. The reaction solution was evenly divided into two 50 mL tubes, followed by adding 20 mL ethanol in each tube for centrifugation (6000 rpm, 5 min). After washing with ethanol for three more times, oleate-capped upconverting nanoparticles were stored in 10 mL cyclohexane for silica coating.
Synthesis of silica-coated NaYF4: Yb,Er,Tm upconversion nanoparticles with tunable shell thickness
The coating of upconversion nanoparticles with silica was achieved by a modified reverse micro-emulsion method. Cyclohexane-dispersed UCNPs (20 mg/mL) with various amount of volume (1, 0.5, or 0.2 mL) were diluted by adding pure cyclohexane solvent to 2 mL, and then got transferred to a 60 mL glass bottle. After that, 8 mL of cyclohexane and 0.5 mL of Triton X-100 were added into the bottle along with about 2 min ultrasonication. Subsequently, 0.5 mL of Triton X-100 and 0.12 mL of ammonium hydroxide (25-28 wt%) was added into the mixture under ultrasonication for about 20 min, yielding a transparent solution. Then, 40 L of TEOS were added and the mixture was ultrasonicated for 2 min, followed by magnetic stirring at room temperature for 48 h. The silica-coated NaYF4:Yb,Er, Tm UCNPs were collected by centrifugation, washed with ethanol three times, and finally dispersed in different NaCl concentration of aqueous solution at different pH values.
Results and Discussion
Characterization of NaYF4: Yb,Er,Tm and NaYF4: Yb,Er,Tm@SiO2 nanoparticles
UCNPs (Y:Yb:Er:Tm=77.5:20:2:0.5) were synthesized by using a previously reported method with modifications[27]. The TEM image shows that the as-prepared nanoparticles have uniform size and morphology of hexagonal shape (Figure 1). The average diameter of these particles was about 40 nm, suitable for biological applications. The surface of these UCNPs was capped by oleic acid, making them hydrophobic and preventing them from biological applications. To address this problem, we coated these UCNPs with a shell layer of silica that makes the core-shell water soluble. The silica coating strategy had a number of advantages for bioapplications: (i) the multi-valency of an extensively polymerized polysilane ensures that these UCNPs stay soluble, providing a spatial isolation of UCNPs from the performance-degrading substances in the environment; (ii) the silica was known to be biocompatible, chemically inert and optically transparent at visible and near infrared wavelengths [28], (iii) the chemistry of silica was well investigated, which could incorporate different functional groups (-COOH, -NH2, and -SH) to control the interactions with biological environments. Moreover, the ability to control the shell thickness was of particular importance to probe the shell effect on the properties of UCNPs as well as the use of them as biolabels. To realize a tunable shell thickness of silica coating, we varied the ratio between the concentration of UCNPs and the concentration of tetraethyl orthosilicate (TEOS) while maintaining all other parameters unchanged. As one can see in Figure 2a-d, monodisperse UCNP@SiO2 core/shell nanoparticles with uniform shell thickness varying from 3-16 nm were synthesized successfully. An UCNP@SiO2-3 nm core/shell nanoparticle with 3 nm thick silica shell was obtained when 1 mL of cyclohexane-dispersed UCNPs were added to the reaction system, while 16 nm thick silica shell was obtained when 0.2 mL UCNPs were added. The larger the ratio of the concentration of UCNP versus the concentration of TEOS, the thinner the resulting silica shell thickness.
3The photoluminescence spectra and stability of NaYF4: Yb, Er,Tm@SiO2
Photoluminescence spectra of silica coating of UCNPs with different thickness were measured by excited at 980 nm with a power density of 10 W/cm2. The emission peaks of UCNPs@SiO2 at 540, 650 and 800 nm were observed, corresponding to the 2H11/4S3/2→4I15/2 and the 4F9/2 → 4I15/2 transitions of ErE+ ions and the 3H4→3H6 transition of Tm3+ ions, respectively (Figure 2e). Along with an increase of the thickness of the silica shell, we observed that the NIR peak at 800 nm increase accordingly. The NIR emission intensity for the aqueous sample with 36 nm SiO2 shell thickness can be about ~ 3 times higher than that from UCNPs with 3 nm shell thickness. This intensity increase indicate that the shell of SiO2 is able to prevent UCNPs from luminescence quenching by the spatial isolation of UCNPs from quenchers in the aqueous environment (such as high vibration energy from OH group). A thicker SiO2 shell create better spatial isolation, and thus brighter upconversion luminescence. Note that the emission peaks at 540/650 nm slightly decreases with an increment of the SiO2 shell thickness. The observed modulation behavior by the SiO2 shell thickness for emission bands at different wavelengths might be attributed to the scattering (or refraction) difference of silica at those wavelengths, with less scattering at long emission wavelengths. It should be noted that the NIR emission at 800 nm when excited at 980 nm from aqueous UCNPs@SiO2 nanoparticles are of critical importance for their future use in bioimaging. This is because both the excitation and the emission wavelengths fall within the “optical transmission window” for biological tissues in the NIR range (~700-1000 nm)9/sup> allowing not only a deep light penetration and reduced photodamage but also low auto fluorescence and light scattering.
To test the colloidal-stability of UCNPs@SiO2 nanoparticles, the prepared UCNPs@SiO2-3 nm nanoparticles were dissolved in 0, 0.25, 0.50, 0.75, 1.0 M NaCl solution, with pH values of 3, 5, 7, 9, 11, respectively. It is known that the colloidal stability strongly depends on the surface charge of the dispersed particles, of which the same charge provides the repulsion force to prevent the colloidal particles from agglomerating. If the charge on the colloid was reduced or eliminated, the stability of the colloidal particles would be lost or degraded. Obvious aggregation was observed 2 min after adding into 0.25, 0.50, 0.75, 1.0 M NaCl solution, and the aggregation became more obvious with the increase of NaCl concentration. However, aggregation was not observed in the 0 M NaCl solution even several hours after dispersing in water (Figure 3). It is known that the NaCl solution was a strong electrolyte, and the positive charged of sodium ions could neutralize the negative charge of the coated silica shell. The charge repulsion between the particles was thus decreased, resulting in particle aggregation and sinking to the bottom. We also investigated the stability of NaYF4: Yb, Er, Tm@SiO2 nanoparticles in NaCl-free solution at pH values from 3-11 (Figure 4). The nanoparticles in the pH = 7 solution was the most stable, forming clear solution without precipitation over 5 h. While the nanoparticle solution was most unstable at pH = 3 solution, the precipitation could be observed after about 1 min. For weak acid or alkaline solution, the stability of the specific nanoparticles was superior to that at pH=3, but inferior than at pH=7. The combined results in Figure 3 and Figure 4 indicated that the silica-coating make UCNPs stable at neutral aqueous environment free of electrolyte. For the electrolyte-containing biological environments, further surface modification of silica coating was needed such as polyethylene glycol (PEG) to improve blood-circulation capability.
Conclusion
We report on a modified reverse microemulsion approach to yield uniform silica coating of NaYF4: Yb, Er, Tm UCNPs with a controlled thickness (3-16 nm). A simple increase of the concentration of UCNPs while maintaining the TEOS concentration constant could gradually decrease the silica shell thickness. Moreover, stability investigations revealed that the silica-coated UCNPs are most stable at sodium chloride-free solution and with pH=7. The stable, monodisperse, and uniform silica-coated UCNPs in aqueous solution have implications for applications in bioimaging.
Acknowledgement
This work is supported by National Natural Science Foundation of China (51672061), and the Fundamental Research Funds for the Central Universities (Grant AUGA5710052614, AUGA8880100415, and HIT.BRETIV.201503).
Conflict of Interest
We declare that we have no financial and personal relationships with other people or organizations that can inappropriately influence our work, there is no professional or other personal interest of any nature or kind in any product, service and/or company that could be construed as influencing the position presented in, or the review of, the manuscript entitled.
- Guo H, S Sun (2012) Lanthanide-doped upconverting phosphors for bioassay and therapy. Nanoscale 4: 6692-6706. Link: https://goo.gl/5dbdZT
- Zhou J, Liu Z and Li F (2012) Upconversion nanophosphors for small-animal imaging. Chem Soc Rev 41: 1323-1349. Link: https://goo.gl/yTxLJe
- Ang LY, Lim ME, Ong LC, Zhang Y (2011) Applications of upconversion nanoparticles in imaging detection and therapy. Nanomedicine 6: 1273-1288. Link: https://goo.gl/DJ31YI
- Deng ML, Ma YX, Huang S,Hu GF, Wang LY (2011) Monodisperse upconversion NaYF 4 nanocrystals: syntheses and bioapplications. Nano Research 4: 685-694. Link: https://goo.gl/BBPlX4
- Wang M, Abbineni G, Clevenger A, Mao CB, Xu SK (2011) Upconversion nanoparticles: synthesis, surface modification and biological applications. Nanomedicine 7: 710-729. Link: https://goo.gl/zpFxXD
- Vetrone F, Naccache R, Juarranz De La Fuente A, Sanz-Rodríguez F, Blazquez-Castro A, et al. (2010) Intracellular imaging of HeLa cells by non-functionalized NaYF 4 : Er3+, Yb3+ upconverting nanoparticles. Nanoscale 2: 495-498. Link: https://goo.gl/TwYm7Y
- Chatterjee DK, Gnanasammandhan MK, Zhang Y (2010) Small upconverting fluorescent nanoparticles for biomedical applications. Small 6:2781–2795. Link: https://goo.gl/bwNPtW
- Mader HS, Kele P, Saleh SM, Wolfbeis OS (2010) Upconverting luminescent nanoparticles for use in bioconjugation and bioimaging. Curr Opin Chem Biol 14: 582-596. Link: https://goo.gl/EYqJ2O
- Damasco JA, Chen GY, Shao W, Ågren H, Huang HY, et al. (2014) Size-tunable and monodisperse Tm3+/Gd3+-doped hexagonal NaYbF4 nanoparticles with engineered efficient near infrared-to-near infrared upconversion for in vivo imaging. ACS Appl Mater Interfaces 6: 13884–13893. Link: https://goo.gl/jlNEML
- Amstad E, Textor M, Reimhult E (2011) Stabilization and functionalization of iron oxide nanoparticles for biomedical applications. Nanoscale 3: 2819-2843. Link: https://goo.gl/E8Pdxy
- Li Z, Zhang Y, Jiang S (2008) Multicolor core/shell-structured upconversion fluorescent nanoparticles. Adv Mater 20: 4765-4769. Link: https://goo.gl/Uyc05L
- Wang GF, Peng Q and Li YD (2009) Upconversion luminescence of monodisperse CaF2:Yb3+/Er3+ nanocrystals. J Am Chem Soc 131: 14200-14201. Link: https://goo.gl/OWP3cM
- Yang J, Zhang CM, Peng C, Li CX, Wang LL, et al. (2009) Controllable red, green, blue (RGB) and bright white upconversion luminescence of Lu2O3:Yb3+/Er3+/Tm3+ nanocrystals through single laser excitation at 980 nm. Chem. Eur 15: 4649-4655. Link: https://goo.gl/wVyJ79
- Shan JN, Qin X, Yao N and Ju YG (2007) Synthesis of monodisperse hexagonal NaYF 4 :Yb, Ln (Ln = Er, Ho and Tm) upconversion nanocrystals in TOPO. Nanotechnology 18: 16700. Link: https://goo.gl/u2WGtU
- Li LeLe, Zhang RB,Yin LL, Zheng KZ,Qin WP, et al. (2012) Biomimetic surface engineering of lanthanide-doped upconversion nanoparticles as versatile bioprobes. Angew Chem Int Ed 51: 6121-6125. Link: https://goo.gl/6O17uA
- Qiao XF, Zhou JC, Xiao JW, Wang YF, Sun LD, et al. (2012) Triple-functional core-shell structured upconversion luminescent nanoparticles covalently grafted with photosensitizer for luminescent, magnetic resonance imaging and photodynamic therapy in vitro. Nanoscale 4: 4611-4623. Link: https://goo.gl/7lEs9b
- Wang M, Mi CC, Wang WX, Liu CH, Wu YF, et al. (2009) Immunolabeling and NIR-excited fluorescent imaging of HeLa cells by using NaYF 4 :Yb,Er upconversion nanoparticles. ACS Nano 3: 1580-1586. Link: https://goo.gl/QuthTn
- Hu H, Xiong LQ,Zhou J,Li FY,Cao TY, et al. (2009) Multimodal-luminescence core-shell nanocomposites for targeted imaging of tumor cells. Chemistry 15: 3577-3584. Link: https://goo.gl/pFWTH4
- Wu ZN, Guo CR, Liang S, Zhang H, Wang LP, et al. (2012) A pluronic F127 coating strategy to produce stable up-conversion NaYF 4 :Yb,Er(Tm) nanoparticles in culture media for bioimaging. J. Mater Chem 22: 18596-18602. Link: https://goo.gl/1QlFTc
- Wu ZJ, Li H, Liu ZH (2015) An aptasensor for carcinoembryonic antigen based on upconversion fluorescence resonance energy transfer. Sensors and Actuators B 206: 531–537. Link: https://goo.gl/0VI0HH
- Jiang S, Zhang Y (2010) Upconversion nanoparticle-based FRET system for study of siRNA in live cells. Langmuir 26: 6689-6694. Link: https://goo.gl/eE2yGj
- Li ZQ and Zhang Y (2006) Monodisperse silica-Coated polyvinylpyrrolidone/NaYF 4 nanocrystals with multicolor upconversion fluorescence emission. Angew Chem 45: 7732–7735. Link: https://goo.gl/IzmZmp
- Wang M, Hou W, Mi CC, Wang WX, Xu ZR, et al. (2009) Immunoassay of goat antihuman immunoglobulin G antibody based on luminescence resonance energy transfer between near-infrared responsive NaYF 4 :Yb,Er upconversion fluorescent nanoparticles and gold nanoparticles. Anal Chem 81: 8783-8789. Link: https://goo.gl/ieI9kD
- Chen H, Hu H, Yu M, Li F, Zhang Q, et al. (2008) Versatile synthesis strategy for carboxylic acid-functionalized upconverting nanophosphors as biological labels. J Am Chem Soc 130: 3023-3029. Link: https://goo.gl/mBH3CL
- Boyer JC , Manseau MP, Murray JI , Van Veggel FC (2010) Surface modification of upconverting NaYF 4 nanoparticles with PEG-phosphate ligands for NIR (800 nm) biolabeling within the biological window. Langmuir 26: 1157-1164. Link: https://goo.gl/p4LUdd
- Morel AL, Nikitenko SI, Gionnet K, Wattiaux A, Lai-Kee-Him J, et al. (2008) Sonochemical approachtothe synthesis of Fe3O4@SiO 2 core shell nanoparticles with tunable properties. ACS Nano 2: 847-856. Link: https://goo.gl/9EGDGR
- Li Z, Zhang Y (2008) An efficient and user-friendly method for the synthesis of hexagonal-phase NaYF 4 :Yb, Er/Tm nanocrystals with controllable shape and upconversion fluorescence. Nanotechnology 19: 345606. Link: https://goo.gl/AVneFe
- Liu F, Zhao Q, You H, Wang Z (2013) Synthesis of stable carboxy-terminated NaYF 4 : Yb3+, Er3+@SiO 2 nanoparticles with ultrathin shell for biolabeling applications. Nanoscale 5: 1047-1053. Link: https://goo.gl/jiM59E
- Mader HS, Link M, Achatz DE, Uhlmann K, Li XH, et al. (2010) Surface-modified upconverting microparticles and nanoparticles for use in click chemistries. Chem. Eur 16: 5416–5424. Link: https://goo.gl/OQ4dbA
Article Alerts
Subscribe to our articles alerts and stay tuned.
 This work is licensed under a Creative Commons Attribution 4.0 International License.
This work is licensed under a Creative Commons Attribution 4.0 International License.

Save to Mendeley
Save to Mendeley
